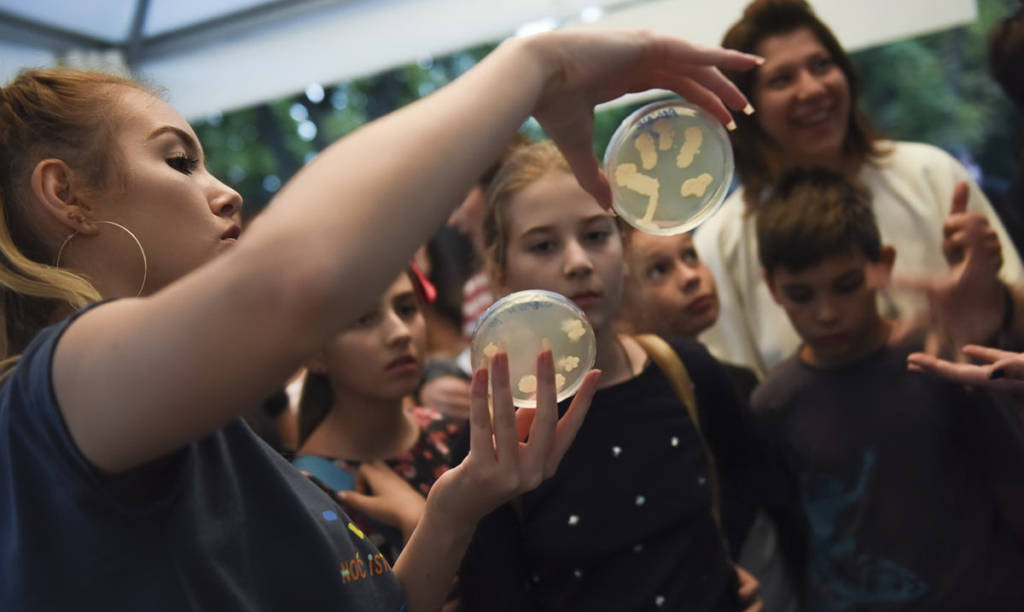

Poslednjeg petka u septembru, u više od 250 evropskih gradova održaće se 12. Noć istraživača, manifestacija čiji je cilj da pre svega mladima, približi posao istraživača, naučnika.
U Srbiji osma Noć istraživača biće održana u jedanaest gradova širom zemlje (Beogradu, Novom Sadu, Kragujevcu, Nišu, Pirotu, Požarevcu, Petnici, Inđiji, Zrenjaninu, Šapcu i Subotici), ove godine pod sloganom „ZNANJE NA PRVI OGLED!“
Na nacionalnoj pres konferenciji, održanoj danas u zgradi Rektorata novosadskog Univerziteta, o detaljima programa u svakom gradu, govorili su Jovana Zdjelarević, Information and Media Officer, EU Info Point Novi Sad, Marjana Brkić istraživač-saradnik Instituta za biološka istraživanja Siniša Stanković, koordinator projekta “ReFocuS” Noć istraživača, Institut za biološka istraživanja “Siniša Stanković” Univerzitet u Beogradu, Marko Grković, direktor Zavoda za zaštitu spomenika kulture Kragujevac, dr Aleksandra Pavlović, vanredni profesor PMF Niš i prof. dr Tijana Prodanović, redovni profesor PMF, Novi Sad.
„Svake godine prikazujemo i približavamo druge nauke i istraživače da bismo pokazali raznovsnost ali i međusobnu povezanost različitih nauka u Srbiji. U vremenu kada smo okruženi savremenim tehnologijama i kada nam je svaka informacija dostupna za nekoliko klikova, veoma je teško zainteresovati mlade, a još teže ih zadržati naučnim igrarijama. Verovali ili ne, većina stanovnika planete koristi internet i mobilne telefone, a ne zna na kojim principima oni rade. E zbog toga smo mi tu, da im probudimo istraživački duh. Ne moraju da postanu istraživači kada porastu, ali želimo da nastave da istražuju i da ne izgube dečju znatiželju tokom odrastanja“, rekla je dr Tanja Adnađević, naučna saradnica Instituta za biološka istraživanja Siniša Stanković i koordinatorka Noći istraživača.
U okviru ReFocuS projekta, migracije će biti glavna tema Noći istraživača, 29. septembra od 17 do 22 časa, u Beogradu, Kragujevcu, Nišu, Pirotu, Petnici, Inđiji i Požarevcu.
U Beogradu istraživači će dočekivati posetioce, na čak deset lokacija, i to u Francuskom institutu, Gete institutu, Galeriji nauke i tehnike SANU, Muzeju Vuka i Dositeja, Naučnom klubu Beograd, Kalemegdanu (Savskom šetalištu, Fontani Borba, Muzičkom paviljonu i Letnjoj sceni) i po prvi put u tržnom centru Big Fashion.
U Požarevcu akcenat je na gljivama i antibioticima a posetioci ce imati priliku da saznaju šta je to drugačije među narodima kad je u pitanju mozak. Niš na čak četiri lokacije (Niška tvrđava, Univerzitetska biblioteka, Narodni muzej i Medijana) predstavlja istraživački posao kroz upoznavanje rimske vile, lokalitet Medijana kroz mape koje skrivaju odgovore i istraživanje vakuuma. Kragujevac je za osmu Noć istraživača spremio pravu arheološku igraonicu gde će posetioci učestvovati na pravim arheološkim iskopavanjima,dešifrovati hijeroglife i tako upoznati drevnu egipatsku civilizaciju ali i pomoći Kolumbu da otputuje do Amerike.
U Pirotu će se 29. septembra pričati o migraciji senki, tektonskim pločama na Zemlji, uzrocima zemljotresa i vulkana kao i raznolikosti i širenju engleskog jezika u svetu.
Evolucija mozga, migracije ljudi i navike u ishrani kao i migracije ćelija i molekula biće glavne teme Noći istraživača u Petnici.
Koji su strahovi zastupljeni kod različitih naroda danas i čega su se plašili Egipćani a čega Inke i praistorijski ljudi jesu samo neka od pitanja čije će odgovore dobiti posetioci ove naučne fešte u Inđiji.
“Ovogodišnju Noć istraživača smo posvetili HOT nauci odnosno gorućim temama i pitanjima iz nauke i visokim temperaturama, čime, nakon prošlogodišnje COOL nauke zaokružujemo dvogodišnji projekat Cool&Hot Noć istraživača. Naime, osim toga što se kroz ovakve manifestacije konstantno trudimo da širimo i negujemo ljubav i interesovanje, kako mladih tako i šire javnosti prema nauci, ove godine smo želeli da skrenemo pažnju na aktuelna istraživanja kojim se bave naši naučnici. Istraživačke grupe iz Srbije, i pored zaista velikih izazova sa kojima se već godinama nosi nauka u zemlji, daju rezultate koji su u rangu svetske nauke. Naše HOT istraživačke grupe i goruće teme kojima se oni bave će Novosađani moći da upoznaju u toku septembra na bilbordima po gradu, ali i u opuštenom razgovoru na “Kafi sa naučnicima” u samoj Noći istraživača u TC Big. A da nauka zna da bude i zabavna, dokazaće mladi posetioci u potrazi za dobrim provodom, koji će nam se pridružiti u centru Startit i doći maskirani u svoje naučne idole, superheroje, fenomene ili bilo šta što ima veze sa naukom” rekla je između ostalog, profesorka dr Tijana Prodanović.
U Novom Sadu, Zrenjaninu, Subotici i Šapcu od 16 časova pa sve do ponoći, posetioci će imati priliku da vide mnogobrojne „VRUĆE“ eksponate i učestvuju u interaktivnim radionicama kojima je cilj da pokažu da se i naučnici u Srbiji bave „gorućim“ temamam. Već tradicionalno, program za najmlađe počinje od 16 sati – Naučno igralište, a do 22 sata će posetioci uživati u zanimljivim eksponatima, interesantnim radionicama, uz toplu čokoladu razgovarati sa naučnicima… Oni stariji pozvani su u klub Startit od 19 sati, gde ih čeka predavanje o društvenim mrežama, virtuelnom scenskom dizajnu, direktna veza sa naučnicima u CERN-u, naučni maskenbal i po običaju, odlična svirka.
Kao uvod u ovu Noć, Novosađani su pozvani da već 22. septembra prisustvuju naučno-popularnom predavanju najboljeg mladog naučnika novosadskog PMF-a, Tina Lukića u klubu STARTIT, od 20 sati. Za one nestrpljive, klub Starit će već od 10. septembra biti domaćin kompletne interaktivne izložbe „Spektri“ Centra za promociju nauke.
Posebnu pažnju novosađanima skrećemo na Naučni kamion, koji se svake godine nalazi u dugom gradu. U nedelji u kojoj će se održati Noć istraživača, Naučni kamion Centra za promociju nauke će prvi put gostovati u Novom Sadu!
Tokom cele nedelje prizemlje Naučnog kamiona će biti domaćin dela interaktivne izložbe „Spektri“ koja će moći da se pogleda svakog dana od 25.9. do 29.9. u periodu od 16h-22h, dok će se na spratu odvijati naučno-popularni program koji su pripremili nastavnici i učenici novosadskih osnovnih i srednjih škola.
Naučni kamion je ove godine već obišao Pirot, Užice, Leskovac, Smederevo i Suboticu.
Naučno-popularni program od 16 pa do 22 sata, očekuje i Zrenjanince u Kulturnom centru, Subotičane kod Zelene fontane i Šapčane na Glavnom trgu.
Noć istraživača finansirana je iz programa „HORIZON 2020“ koji predstavlja najveći program Evropske unije za istraživanje i inovacione delatnosti, a u okviru potprograma Marija Sklodovska-Kiri.
U Srbiji pod imenom Noć istraživača postoje dva projekta ReFocuS i Cool&Hot.
Koordinator ReFocuS projekta je Institut za biološka istraživanja “Siniša Stanković” sa partnerima Prirodno matematičkim fakultetom iz Niša, Zavodom za zaštitu spomenika kulture Kragujevac i Centrom za promociju nauke.
Projekat Cool&Hot koordinira Fakultet tehničkih nauka Novi Sad sa partnerima Prirodno matematičkim fakultetom iz Novog Sada, Kreativno edukativnim centrom, Visokom tehničkom školom strukovnih studija Zrenjanin, Udruženjem naučnih komunikatora i Centrom za promociju nauke.
